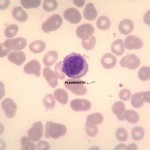
Foto da extensão sanguínea 1
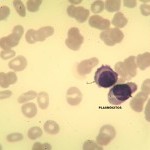
Foto da extensão sanguínea 2
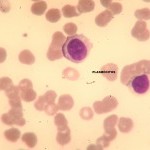
Foto da extensão sanguínea 3
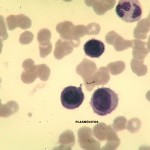
Foto da extensão sanguínea 4
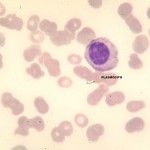
Foto da extensão sanguínea 5
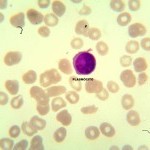
Foto da extensão sanguínea 6
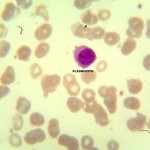
Foto da extensão sanguínea 7
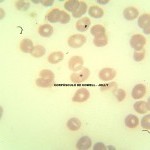
Foto da extensão sanguínea 8
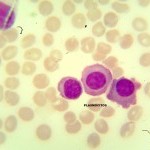
Foto da extensão sanguínea 9
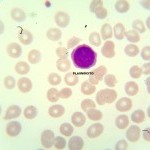
Foto da extensão sanguínea 10
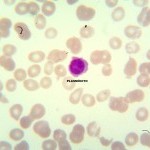
Foto da extensão sanguínea 11

Caso nº 6
Caso Clínico #8
Local: Curitiba-PR
Mês / Ano: Julho/2015
Assuntos relacionados: Mieloma. Sexo Masculino
Quadro Clínico
Paciente do sexo masculino, 76 anos.
Com base nos dados clínicos e laboratoriais, propomos as seguintes questões para discussão do caso:
Com base no resultado do hemograma e nas fotos da extensão sanguínea indique a hipótese diagnóstica laboratorial e faça uma breve discussão sobre sua escolha.
Referências Bibliográficas
SILVA, Paulo Henrique, et al. Hematologia Laboratorial: teoria e procedimentos. Porto Alegre, Ed. Artmed, 2016.
Dados Laboratoriais
-
HEMOGRAMA
Eritrócitos
3.450.000/uL
Hemoglobina
9,0 g/dL
Volume globular
28,0%
VCM
81,1 fL
HCM
26,0%
CHCM
32,1%
Leucócitos
10.300/uL
Plaquetas
20.000/uL
Linfócitos
20%
Monócitos
02%
Bastonetes
09%
Segmentados
29%
Plasmócitos
40%
Respostas da discussão
Hipótese diagnóstica laboratorial
Mieloma.
Discussão do caso laboratorial
O que chama a atenção nas fotos da extensão sanguínea é a presença de plasmócitos (40% na contagem relativa) e a presença de roleaux eritrocitário. O roleaux eritrocitário pode ser visto em todas as fotos. A foto 08 mostra a presença de um corpúsculo de Howell - Jolly, o que é um achado e não tem significado para o diagnóstico. Sempre que houver a presença de plasmócitos (não importa a quantidade) associado com roleaux eritrocitário deve-se pensar em mieloma.
Os sintomas clínicos mais frequentes do mieloma são dores ósseas devido a proliferação dos plasmócitos, inclusive os pacientes podem fazer fraturas ósseas, insuficiência renal e processos infecciosos. A insuficiência renal resulta da excreção de cadeias leves de imunoglobulinas, chamada de proteína de Bence Jones, e da hipercalcemia. A causa dos processos infecciosos é a hipogamaglobulinemia associada a uma imunodeficiência celular. A medula óssea, ao diagnóstico, mostra mais de 5% de plasmócitos em 90% dos casos. Geralmente o número de plasmócitos está em torno de 30%.
A intensidade da anemia é variável, resulta de uma resposta inapropriada a eritropoietina e agravada pela insuficiência renal. Geralmente a concentração de hemoglobina fica em torno de 7 a 12g/dl e é normocítica e normocrômica. A série vermelha tem como alteração característica a formação de roleaux eritrocitário. A contagem diferencial, geralmente, mostra leucopenia com neutropenia e com poucas células plasmáticas nos estágios iniciais da doença. Os pacientes, geralmente, não manifestam trombocitopenia significativa, também, podem, apresentam episódios hemorrágicos em função da trombocitopenia e de alterações dos fatores da coagulação.
Uma proteína monoclonal (proteína M) é detectada na eletroforese de proteínas nas bandas beta ou gama, 90% dos pacientes apresentam a proteína M no soro e 80% na urina. Em torno de 55% dos pacientes a proteína M é IgG, 25% tem IgA, 1% tem IgD, 1% IgM e cerca de 20% secretam somente cadeia leve. A VHS é extremamente elevada em função da alta produção de imunoglobulina. Outra característica laboratorial do MM é a coloração da extensão sanguínea, que em função da concentração de imunoglobulina fica com uma coloração azul intenso.
Os critérios mínimos para o diagnóstico definitivo do mieloma são:
- mais de 10% de plasmócitos na medula óssea;
- proteína M no soro acima de 3,0 g/dL e na urina acima de 1,0 g/dL;
- lesões osteolíticas.